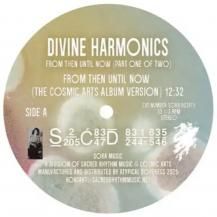
KUNIYUKI TAKAHASHI / JOAQUIN JOE CLAUSSELL / DIVINE HARMONICS PT4

AL KENT / MILLION DOLLAR DISCO EDITS (USED) AOW03
Label : ALL OUT WAR (UK)
Format : 12"
Release : 2010年
Tracklist
A-SIDE
Delirious
B-SIDE
Brock Party
ジャケット状態 : ブラックスリーヴ
盤状態 : B
★コンディションはこちらから★
特記事項
盤面に再生に影響のない若干のスレがあります。
【屈指のディスコディガーAl KENTによるグッドディスコ12インチ!!】
※こちらはUSED商品になります。
※中古盤のコンディション表記と実際のコンディションに大幅な違いがあった場合のみ返品をお受け致します。
※商品は一点物となるため交換等お受け出来ません。
※商品に関するご質問など『お問い合わせ』よりご連絡ください。
※7インチ、CDの場合)三枚までゆうメール(300円)での発送が可能です。
※(12インチ、LPの場合)一枚まで定形外郵便(650円)での発送が可能です。
※(12インチ、LPの場合)三枚まで定形外郵便(850円)での発送が可能です。(2LPは2枚カウントになります)
※必ず【特定商取引法に基づく表記】をご確認の上お買い求めください。
NO.192
おすすめ商品
-
 さらさ / INNER OCEAN -LP-
さらさ / INNER OCEAN -LP-
FUJIROCKへの出演やLIQUIDROOMワンマン完売など新世代オルタナアイコン・さらさの1stアルバムがLPで登場!
4,400円(税込)
-
 スカートとPUNPEE / ODDTAXI
スカートとPUNPEE / ODDTAXI
TVアニメ「オッドタクシー」OPテーマの、スカートとPUNPEEによる「ODDTAXI」が満を期してアナログ化!
2,200円(税込)
-
KUNIYUKI TAKAHASHI / JOAQUIN JOE CLAUSSELL / DIVINE HARMONICS PT4
KUNIYUKI TAKAHASHI / JOAQUIN JOE CLAUSSELL / DIVINE HARMONICS PT4
Joe Claussell 主宰レーベル Sacred Rhythm Music 人気シリーズ「Divine Harmonics」待望の第4弾!!!
4,880円(税込)
-
 TYLER, THE CREATOR / CHROMAKOPIA -2LP- (WHITE VINYL)
TYLER, THE CREATOR / CHROMAKOPIA -2LP- (WHITE VINYL)
来日公演も大盛況! グラミー受賞ラッパーのタイラー・ザ・クリエイター。7thアルバム。
7,980円(税込)
-
 来海 / Kasabuta (シングル・バージョン) / wolf moon (1月下旬入荷予定)
来海 / Kasabuta (シングル・バージョン) / wolf moon (1月下旬入荷予定)
クニモンド瀧口が生んだ70年代風の情感豊かな名曲を、来海が現代の感性で昇華。新しさと懐かしさが交差する音世界が、待望のアナログ(7インチ)化!
2,500円(税込)
-
 Wa Yo Set / Echoes -LP- (1月下旬入荷予定)
Wa Yo Set / Echoes -LP- (1月下旬入荷予定)
待望の2026年最新アルバムがLPリリース!快進撃の止まらない Wa Yo Set、待望の2026年最新アルバム『Echoes』をついにリリース!
4,620円(税込)
-
 NEW AGE STEPPERS / NEW AGE STEPPERS -LP- (数量限定盤 / 日本語帯付き / 解説書封入)
NEW AGE STEPPERS / NEW AGE STEPPERS -LP- (数量限定盤 / 日本語帯付き / 解説書封入)
エイドリアン・シャーウッド率いるON-U SOUNDのレーベル第一弾リリースにしてポストパンク/UKダブの時代を超越する名盤『New Age Steppers』が日本語帯付きLPで発売!!
4,980円(税込)
-
 Nash Music Library / ハードオフの店内BGM (SC-1903) (2月中旬入荷予定)
Nash Music Library / ハードオフの店内BGM (SC-1903) (2月中旬入荷予定)
ハードオフの店内で耳にするあの名曲が衝撃の公式アナログ化!
2,200円(税込)
-
 DJ HASEBE / BLUE CLUB -LP-
DJ HASEBE / BLUE CLUB -LP-
DJ HASEBEと15組のアーティストによるコラボレーション作品を収録したLPが発売!
4,400円(税込)









